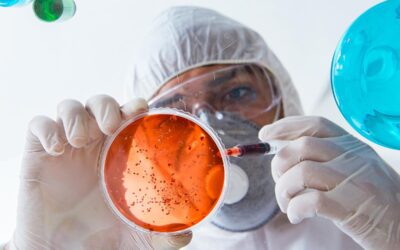

Novedades
Conservantes para bacalao desalado
El manejo y aplicación de los conservantes alimentarios puede ser complejo. Es el caso de la aplicación de conservantes en bacalao desalado. Recientemente la inspección sanitaria…
Enzima alimentaria transglutaminasa (II parte)
La transglutaminasa es una enzima alimentaria ampliamente utilizada en industria alimentaria. La transglutaminasa tiene muchas ventajas y aplicaciones en numerosos grupos de alimentos. Las más comunes son las siguientes…
Mezcla a medida
Los aditivos alimentarios son extremadamente útiles para la industria alimentaria, pero su aplicación y manejo pueden resultar complicados por los siguientes motivos…
Carragenatos E-407 (II parte)
Los carragenatos o carragenanos son aditivos alimentarios complejos en cuanto a su funcionalidad y aplicaciones.
Los carragenatos se clasifican según estos criterios…
Legislación sobre aditivos alimentarios
Los aditivos alimentarios están sometidos a un riguroso control en la Unión Europea. Están regulados por distintas legislaciones que les afectan en varios ámbitos. Estas leyes alimentarias suponen una garantía tanto para la industria alimentaria como para el consumidor final, ya que…
Enzima alimentaria transglutaminasa
La transglutaminasa es una enzima presente en la naturaleza en multitud de seres vivos. De manera natural, la transglutaminasa es capaz de formar uniones covalentes entre residuos libres de los aminoácidos lisina y cisteína…
Carragenatos E-407
Los carragenatos, también llamados carragenanos, son un grupo de aditivos alimentarios ampliamente utilizado en la industria alimentaria. Estos aditivos alimentarios están presentes en la naturaleza en diversos tipos de algas…
Colorante cochinilla E 120
Recientemente se ha publicado el Reglamento (UE) 2018/1472, que modifica parte del Reglamento (CE) 1333/2008 con respecto a la declaración de etiquetado del colorante cochinilla E-120, también llamado carmín, carmines, ácido carmínico o cochinilla…
Conservantes alimentarios
Los conservantes o conservadores son aditivos alimentarios autorizados que se añaden a los alimentos para aumentar su vida útil. Su uso permite…
Bacon reestructurado
Preparado para la fabricación de bacon reconstituido en molde de alto rendimiento. Especialmente indicado para troceados…
SalC50. Reducción de sodio
Sustituto de sal que aporta el 50% del sodio de la sal común. Mantiene el sabor y la funcionalidad. Facilita la fabricación de productos…
Mezclas sinérgicas de lactato y diacetato: CONSERVANTE LD.
Un sustituto eficaz de los conservantes tradicionales. Un producto seguro y con amplio espectro de aplicación en alimentos refrigerados…